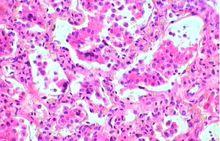

常見種類
可以引起食物中毒或以食品為傳播媒介的致病菌主要有痢疾桿菌,致病性大腸桿菌、沙門氏菌、霍亂弧菌、炭疽桿菌、鼻疽桿菌、結核菌、布氏桿菌、豬丹毒桿菌等。其中:

痢疾桿菌
痢疾桿菌又稱志賀菌,是細菌性痢疾(簡稱菌痢)的病原菌,也可引起食物中毒的發生。屬於志賀氏菌屬,包括志賀氏、福氏、鮑氏和宋內氏等痢疾桿菌。痢疾桿菌為革蘭氏陰性桿菌,無芽孢、無莢膜和無鞭毛。痢疾桿菌的致病力較強,感染10-100個菌即可發病。

致病性大腸桿菌
根據致病機制不同又可分為產腸毒素性大腸桿菌(ETEC)、腸致病性大腸桿菌(EPEC)、侵襲性大腸桿菌(EIEC)、出血性大腸桿菌(EHEC)、腸道聚集黏附性大腸桿菌(EAEC)和志賀氏樣毒素大腸桿菌(SLTEC)六類。各類致病性大腸桿菌可引起嬰兒或成人腹瀉,當其污染食品或飲水後,可引起細菌性食物中毒或水源性腹瀉病暴發流行。

沙門氏菌
屬於腸桿菌科,沙門氏菌屬。為革蘭氏陰性桿菌,呈直桿狀,無芽孢,周毛菌。本菌對光、熱、乾燥和化學消毒劑抵抗力較弱,加熱56~60℃30min、100℃立即死亡,5%的石炭酸2~5min,消毒飲水含氯0.2~0.4mg/L即死亡。

霍亂弧菌
霍亂弧菌為霍亂的病原菌,引起一種急性腸道傳染病,發病急、傳染性強、病死率高,屬於國際檢疫傳染病。霍亂弧菌分為兩類:O1群霍亂弧菌及非O1群霍亂弧菌和O139群霍亂弧菌。霍亂弧菌在形態和生物性狀上都相似,呈逗點狀、香蕉狀,革蘭氏陰性菌,無芽孢,無莢膜,單鞭毛,運動性強。

炭疽桿菌
炭疽桿菌屬於芽孢桿菌屬,為革蘭氏陽性粗大桿菌,兩端平切,排列如竹節狀。為引起動物和人類炭疽的病原菌,主要發生於草食動物,其次是豬,也可傳染於人,是一種烈性傳染病。
鼻疽桿菌

鼻疽桿菌為革蘭氏陰性中等桿菌,無芽孢、莢膜和鞭毛。是鼻疽的病原菌,引起馬、驢、騾、等等一種烈性傳染病,人也可感染。
結核桿菌
結核桿菌屬於分枝桿菌屬的一群細菌,有抗酸性。為革蘭氏陽性,(2~4)μm×(0.3~0.6)μm的細長稍彎的桿菌,需氧、無芽孢、無鞭毛。結核菌為結核病的病原菌,根據致病性可分為人型、牛型、禽型結核分枝桿菌。人型以人的肺結核為主,人型及牛型可在家畜及人中互相感染。

布氏桿菌
布氏桿菌為革蘭氏陰性球桿菌,無鞭毛和芽孢,是布氏桿菌病的病原。

豬丹毒桿菌
豬丹毒桿菌為一種細小桿菌,革蘭氏陽性,無芽孢、無莢膜和無鞭毛,常呈不分枝的長絲狀排列。是引起人畜共患得一種急性、熱性傳染病的病原 。
致病機理
痢疾桿菌其致病作用主要是侵襲力和毒素。病菌黏附於腸黏膜的上皮細胞內,繼而生長繁殖並引起炎症,在內毒素的作用下使腸壁組織壞死,腸功能紊亂,以致出現毒血症。有些痢疾桿菌能產生腸毒素,導致腸炎。
致病性大腸桿菌的污染源是帶菌動物(牛、羊、豬、雞等)和病人及隱形帶菌者。主要通過攝入污染該菌的動物性食品導致發病,或者嚴重污染飲水和其他食品污染及食物鏈的交叉污染也可導致發病。
傷寒和副傷寒病人和健康帶菌者是沙門氏菌的傳染源。病菌隨糞尿排出體外,通過污染的食物、飲水、手、食具或經蠅、蟑螂等媒介污染食物,經口感染。食物或水源污染可導致暴發流行。
霍亂弧菌的傳染源是病人或健康帶菌者,隱性感染者和症狀較輕的患者呈間歇排菌,危害性比重症患者更大。病菌隨糞便及嘔吐物排出,污染飲用水、食物和環境,並通過水、手、污染的食物、食具、蠅、蟑螂等媒介而經口感染。感染人體後,能吸附於腸黏膜表面,並大量繁殖,其內毒素損害腸黏膜,外毒素引起腸液分泌過度增加,發生腹瀉,大量丟失腸液,產生嚴重脫水、酸中毒及電解質紊亂。
炭疽桿菌其致病原因是炭疽桿菌產生的毒素(致死毒素和水腫毒素),人的皮膚傷口通過直接接觸病畜的血液、分泌物、排泄物以及被污染的皮、毛、骨粉等,可引起皮膚炭疽;經口攝入病畜肉類以及被細菌污染的食物和水等,可引起腸型炭疽;吸入帶有炭疽芽孢的塵埃,可引起肺炭疽。
人感染鼻疽桿菌主要是在飼養、治療、屠宰病畜及處理屍體時經損失的皮膚和黏膜感染,也有吃病馬肉受感染的病例,還可通過呼吸道感染。
結核病人通過呼吸道吸入懸浮於空氣中的肺結核而發病。消化道和皮膚傳染較少。病牛及帶菌牛也可污染牛奶而引起人的牛型結核。
布氏桿菌通過皮膚、消化道、呼吸道及眼結膜侵入人體,而以破損皮膚及消化道侵入最為常見。
豬丹毒桿菌通過糞尿、口、鼻、眼分泌物等污染飲水和食物,經消化道和損失的皮膚而感染致病。人主要通過職業途徑和食肉途徑感染。
臨床症狀
細菌性痢疾分為急性和慢性兩類。急性型表現為腹痛、腹瀉、粘液膿血便,里急後重,體溫可高達40℃,治療不徹底可轉為慢性或健康帶菌者。慢性型表現為輕重不等的痢疾症狀,大便帶有黏液或膿血,左下腹壓痛,久病者可貧血、營養不良和神經衰弱等,也可因機體防禦機能下降而發生急性菌痢疾症狀。
大腸桿菌導致的病症一般潛伏期為5~9d。患者呈急性發病,突發性腹痛,水樣糞便,嚴重時轉為血性糞便,嘔吐,低燒或不發熱。重者出現溶血性尿毒綜合徵,如溶血性貧血、血尿、少尿,甚至無尿,急性腎功能衰竭等症狀。
人類沙門氏菌感染的臨床類型主要有3類:①傷寒型,患者出現高熱、皮疹、相對脈緩、肝脾腫大、神經系統中毒症狀。②敗血症,患者潛伏期1~2周,一般發病急,畏寒、發熱,為不規則熱型或間歇熱型。③胃腸炎型,患者潛伏期數小時至3d,體溫一般38~39℃,有的可達40℃以上,食欲不振,噁心、嘔吐、腹痛、腹瀉、稀水樣便、少數有黏液膿血樣便。
霍亂的潛伏期為數小時至7d,發病急。先有頻繁的腹瀉,腹瀉液呈米泔水樣,並有劇烈的嘔吐,呈噴射狀,嘔吐物也呈米泔水樣。導致機體嚴重脫水,外周循環衰竭,血壓下降,脈搏加快,嚴重者可致休克或死亡。
炭疽桿菌的致病原因是其產生的毒素(致死毒素和水腫毒素)。人感染後,經過1~4天的潛伏期,皮膚炭疽的的皮膚浮腫,出現膿包,肺炭疽出現肺炎症狀,腸炭疽引起嘔吐、腹瀉。
人患鼻疽表現為患者體溫升高至40℃,呈弛張熱,伴有惡寒、多汗、頭痛、全身疼痛、乏力和食慾減退,在感染部位形成炎性硬結。
結核菌導致病人出現結核中毒症狀與過敏性增高綜合症、肺結核、頸淋巴結結核、腸結核、結核性腹膜炎、結核性腦膜炎、腎結核、骨關節結核、結核性胸膜炎等。
布氏桿菌病病人潛伏期一般為10~30天,發熱達38~39℃,持續2~3周后退燒。此種熱反覆發作,同時出現全身無力、關節痛、神經痛、肝脾腫大等症狀。
豬丹毒桿菌之人患病時,體溫升至39℃以上,感染的局部皮膚發紅、腫脹、疼痛或有癢感。繼而發展為淋巴管炎、關節炎。
預防措施
開展衛生宣傳教育工作,把好口岸檢疫與食品檢驗關,做好餐飲業的衛生管理工作,讓工作人員養成良好的衛生習慣。加強糞便消毒管理,注意防蠅滅蟲工作。不食腐敗變質和不清潔的食物,避免飲用生水、少吃生菜等,肉類、奶類和蛋類食品食用前煮透,水果要洗淨去皮。對已經污染的水源和環境,技術採取有效消毒措施。及時發現、隔離並治療患病病人,協同防疫部門儘早查清傳染來源,予以根治並進行衛生監督。
檢測方法
食品中致病菌限量標準是食品安全基礎標準的重要組成部分。2012年9月25日衛生部在網站公布食品安全國家標準《食品中致病菌限量》徵求意見稿,首次制定食品中致病菌限量標準。標準提出了沙門氏菌、金黃色葡萄球菌、副溶血性弧菌、單核細胞增生李斯特氏菌、大腸埃希氏菌等幾種主要致病菌在肉製品、水產製品、糧穀類製品、即食加工果蔬、飲料及冷凍飲品等多類食品中的限量要求。其中,公眾比較熟悉的沙門氏菌在各類食品中的限量值均為0,也就是說,樣品中不得檢出這類病菌,金黃色葡萄球菌在各類食品中的限量值均為100 CFU/g。
傳統的微生物檢驗方法是培養分離法,依靠培養基進行培養、分離及生化鑑定。致病菌的檢驗耗時一般時間較長,包括前增菌、選擇性增菌、鏡檢以及血清學驗證等一系列的檢測程式,需要5~7天。相對操作簡單檢測費用較低的是快速檢測試劑盒,適用於食品及水中致病性沙門氏菌、金黃色葡萄球菌、副溶血弧菌、致瀉大腸埃希菌、臘樣芽孢桿菌、板奇腸桿菌檢測的前期增菌預實驗觀察以及大腸菌群污染程度的檢測 。
試劑盒法沙門氏菌快速檢測:在檢測裝置的樣品孔中加入一部分富集培養物,樣品沿檢測裝置流動,出現易於區分的可見結果。如果只在對照區形成一個條帶,則樣品為沙門菌陰性;在對照區和檢測區同時出現條帶,則可初步鑑定樣品為沙門菌陽性 。
測試片法檢測金黃色葡萄球菌:將選擇性培養基中加入專一性的酶顯色劑,並將其載入中紙片上,通過培養,如果樣品中含有金黃色葡萄球菌,即可在紙片上呈現紫紅色的菌落。
微生物專有酶法測定大腸菌群:大腸菌群喔看產生β-半乳糖苷酶,分解液體培養基中的酶底物——4-甲基傘形酮-β-D-半乳糖苷,使4-甲基傘形酮游離,因而在366nm的紫外光燈下呈現藍色螢光。
試紙片法快速測定食品中菌落總數:試紙片為預先製備好的培養基系統,它含有標準培養基、冷水可溶性凝膠和指示劑,便於菌落計數。細菌總數測試片檢樣後37℃培養(48±3)h,陽性菌落在測試片上為紅色或粉紅色,與測試片底色有較大反差,容易判別計數。最適宜計數範圍是每張測試片25~250個菌落。